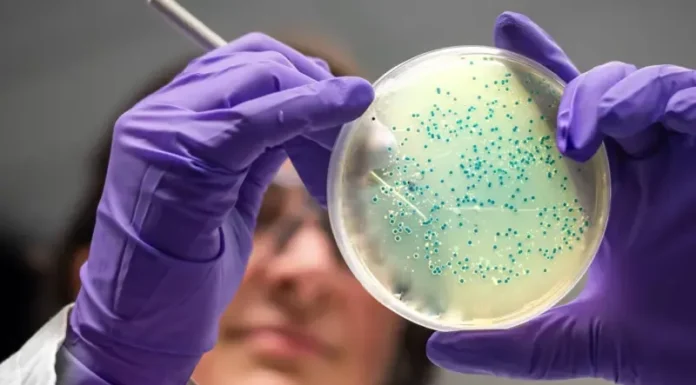

- Advertisement -
KABUL: Researchers have announced the development of two new potential antibiotics through artificial intelligence, capable of eliminating drug-resistant gonorrhea and other superbugs. These antibiotics have been designed at the atomic level using AI and have shown effectiveness in laboratory and animal tests against these formidable microbes. However, these treatments still require years of refinement and clinical trials before they can be used on patients. The MIT research team noted that artificial intelligence could usher in a “second golden age” of antibiotic discovery. While antibiotics are effective at eradicating bacteria, infections that exhibit resistance to treatment kill over a million people each year.